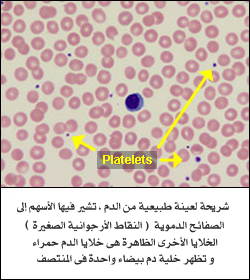

تحليل تِعداد الصفائح الدمويّة
Platelet Count
الغرض من هذا التحليل:
يتم إجراء هذا التحليل لتحديد عدد الصفائح الدمويّة (platelets) فى عينة من دمك كجُزء من الفحص الصِحى. و للكشف عن أو لتشخيص أو لمُراقبة الإصابة بحالات مرضيّة تؤثر على عدد الصفائح الدمويّة ، مثل أمراض النزف أو أمراض نُخاع العظام أو غيرها من الحالات المرضيّة الكامِنة.
يُطلب منك إجراء هذا التحليل فى الحالات التالية:
يُطلب منك إجراء هذا التحليل كجُزء من تحليل صورة الدم الكاملة (CBC) الروتينى. و عندما تُصاب بنوْبات من النزيف غير المُبرّر أو المُستمر لفترات طويلة أو بغيرها من الأعراض المرضيّة التى قد تكون ناتجة عن مرض ما فى الصفائح الدمويّة (platelets).
العينة المطلوبة لإجراء التحليل:
عينة من الدم يتم سحبها من وريد فى ذراعك أو من خلال وَخز الإصبع (فى الأطفال و البالغين) أو وَخز الكاحل (كعب القدم فى الأطفال حديثى الولادة).
تحضيرات قبل إجراء التحليل:
لا يوجد.
كيف يتم التحليل و ماذا يبحث عنه الطبيب؟
الصفائح الدموية، وتسمى أيضا بالصفيحات thrombocytes، هي أجزاء صغيرة من الخلايا وتعد ضرورية لحدوث تخثر الدم بشكل طبيعي. وهي تتكون من خلايا كبيرة جدا تسمى النواء megakaryocytes والتي توجد في نخاع العظام، ثم يتم إطلاقها إلى الدورة الدموية. إن عد الصفائح الدموية هو التحليل الذي يحدد عدد الصفائح الدموية في عينة من دم الشخص.
عند وقوع إصابة لأحد الأوعية الدموية أو أحد الأنسجة وحدوث النزيف، تساعد الصفائح الدموية في وقف النزيف من خلال 3 طرق، وهي:
◊ الالتصاق بموقع الإصابة
◊ التكتل (التجمع) مع الصفائح الأخرى
◊ إطلاق المركبات الكيميائية التي تحفز تجمع الصفائح الدموية الأخرى
هذه الخطوات تؤدي إلى تشكيل سدادة صفيحية رخوة في موقع الإصابة في عملية تسمى الإرقاء الأولي. وفي الوقت نفسه، تدعم الصفائح الدموية المنشطة سلسلة التخثر، وهي سلسلة من الخطوات تشمل تفعيل متسلسل لبروتينات تسمى عوامل التخثر. وعملية الارقاء الثانوي هذه تؤدي إلى تشكيل خيوط الفيبرين التي تتداخل مع السدادة الصفيحية الرخوة، وتشكيل شبكة من الفيبرين، وتنضغط لتشكيل جلطة مستقرة ثابتة في مكانها حتى تلتئم الإصابة، وعندئذ لا تعود هناك حاجة إليها، فتقوم عوامل أخرى بتفتيت الجلطة وإزالتها.
لابد من وجود كل العناصر الابتدائية والثانوية لعملية وقف النزيف (الارقاء)، وأن يتم تنشيطها في الوقت المناسب، وأن تعمل بشكل صحيح ليحدث التخثر. إذا كان هناك نقص في الصفائح الدموية، أو إذا كانت الصفائح الدموية لا تعمل بشكل طبيعي، فقد لا تتكون جلطة مستقرة وربما يتعرض الشخص لخطر متزايد من النزف الشديد.
تبقى الصفائح الدموية في الدورة الدموية لمدة 8-10 أيام تقريبا، ويجب أن يواصل نخاع العظام إنتاج صفائح جديدة بصفة مستمرة لتحل محل الصفائح التي تتحلل أوتستخدم و/ أو تفقد من خلال النزيف. إن تحديد عدد الصفائح الدموية في الدم من خلال عد الصفائح الدموية يمكن أن يساعد في تشخيص مجموعة من الاضطرابات المرتبطة بشدة ارتفاع أو انخفاض عدد الصفائح الدموية.
كيف يتم جمع العينة اللازمة لإجراء هذا التحليل؟
يتم أخذ عينة الدم من وريد بالذراع بواسطة إبرة (حقنة).
هل هناك أى تحضيرات لازمة قبل إجراء التحليل للتأكد من جودة العينة المستخدمة؟
لا توجد حاجة لتحضيرات خاصة.
كيف تتم الاستفادة من هذا التحليل؟
يستخدم عد الصفائح الدموية للكشف عن عدد الصفائح الدموية في الدم. ويندرج هذا التحليل ضمن عد الدم الكامل (CBC)، وهو مجموعة فحوص يتم إجرائها غالبا كجزء من الفحص الصحي العام.
الصفائح الدموية عبارة عن شظايا صغيرة من الخلايا، وهي ضرورية لتخثر الدم الطبيعي. ويمكن استخدام عد الصفائح الدموية للكشف عن أو لتشخيص عدة أمراض وحالات مختلفة قد تسبب مشاكل مع تكوين الجلطة، كما يمكن استخدامه كجزء من فحص تشخيصي لاضطرابات النزيف وأمراض نخاع العظام أو اضطراب فرط تخثر الدم، على سبيل المثال لا الحصر.
ويمكن استخدام الفحص كأداة متابعة للأشخاص الذين يعانون من حالات أساسية كامنة أو يخضعون للعلاج بأدوية معروفة بتأثيرها على الصفائح الدموية. ويمكن أيضا أن يستخدم لمراقبة من يعالجون من اضطراب الصفائح الدموية لتحديد مدى فعالية العلاج.
يمكن إجراء عد الصفائح الدموية بالتزامن مع واحد أو أكثر من فحوص وظيفة الصفائح الدموية، والتي تقيم وظيفة الصفائح الدموية، وغيرها من الفحوص التي تقيم التخثر مثل سلف ثرمبوبلاستين البلازما PT وزمن الثرمبوبلاستين الجزئي PTT. إذا كانت النتائج لا تقع ضمن الوقت الطبيعي، يمكن إجراء بعض الفحوص الأخرى للمساعدة في اكتشاف السبب. وأحيانا تؤخذ مسحة الدم خلال المتابعة لفحص الصفائح الدموية تحت المجهر. وهذا من شأنه أن يساعد على تحديد، على سبيل المثال، ما إذا كان عدد الصفائح الدموية كان منخفضا حقا أم أنها قد تجمعت سويا أثناء الفحص.
متى يُطلب إجراء هذا التحليل؟
غالبا ما يُطلب عدد الصفائح الدموية كجزء من عد الدم الكامل (CBC)، والذي يمكن أن يتم خلال فحص صحي روتيني.
قد يُطلب إجراء الفحص إذا كان الشخص لديه العلامات والأعراض المصاحبة لانخفاض الصفائح الدموية أو أحد اضطرابات النزيف، مثل:
◊ كدمات مجهولة السبب أو سهولة حدوثها
◊ استمرار النزيف من جروح صغيرة لفترة طويلة
◊ تكرار نزيف الأنف
◊ نزيف الجهاز الهضمي (يمكن الكشف عنه في عينات البراز)
◊ نزيف الحيض الشديد
◊ بقع حمراء صغيرة على الجلد تسمى حبرات - قد تبدو أحيانا مثل طفح جلدي
◊ بقع أرجوانية صغيرة على الجلد تسمى فرفرية وتحدث بسبب نزيف تحت الجلد
๏ يمكن أيضا أن يجرى هذا الفحص عند الاشتباه في أن الفرد لديه عدد كبير جدا من الصفائح الدموية. وجود فائض من الصفائح الدموية يمكن أن يسبب فرط التخثر أو في بعض الأحيان النزيف إذا كانت الصفائح الدموية لا تعمل بشكل صحيح. ومع ذلك، فإن الأشخاص الذي لديهم عدد كبير جدا من الصفائح الدموية لا تظهر عليهم علامات أو أعراض في أغلب الأحيان، ولذلك لا يمكن اكتشاف هذه الحالة إلا عند إجراء عد الصفائح الدموية كجزء من فحص طبي أو لأسباب أخرى.
ما هى نتائج هذا التحليل و ماذا تعنى؟
عندما يكون عد الصفائح الدموية منخفضا، يسمى ذلك نقص الصفيحات الدموية، ويمكن أن يحدث مع الأعراض والعلامات المصاحبة بسبب عدد من الحالات والعوامل. عادة ما تندرج الأسباب ضمن إحدى هاتين الفئتين العامتين:
◊ أمراض تجعل نخاع العظام لا ينتج ما يكفي من الصفائح الدموية
◊ الحالات التي تستخدم فيها الصفائح الدموية أو يتم تدميرها بمعدل أسرع من المعتاد
أمثلة من الحالات التي تتسبب في انخفاض عدد الصفائح الدموية وتشمل:
◊ نقص الصفيحات مجهول السبب (ITP) ويعرف أيضا باسم فرفرية نقص الصفيحات المناعي، يحدث نتيجة لإنتاج أجسام مضادة تهاجم الصفائح الدموية.
◊ العدوى الفيروسية مثل كثرة الوحيدات أو التهاب الكبد أو نقص المناعة البشرية أو الحصبة.
◊ بعض الأدوية مثل الأسبرين والإيبوبروفين، وبعض المضادات الحيوية (وتشمل تلك التي تحتوي على السلفا)، والكولشيسين والإندوميثاسين، وعوامل حصر H2، والهيدرالازين، الأيزونيازيد والكينيدين، وأدوية الثيازيد المدرة للبول، والتولبوتاميد، تمثل عدد قليل من الأدوية التي ترتبط مع نقص عدد الصفائح الدموية الناجم عن الأدوية.
◊ نقص الصفيحات الناجم عن الهيبارين (HIT) يؤدي إلى انخفاض الصفائح الدموية عندما يبدأ إنتاج أجسام مضادة لدى الشخص الذي يتلقى العلاج بالهيبارين.
◊ ابيضاض الدم، وسرطان العقد الليمفاوية، أو سرطان آخر (نقيلي) انتشر إلى نخاع العظام- غالبا ما يتعرض مرضى السرطان للنزيف بسبب انخفاض عدد الصفائح الدموية بشكل ملحوظ. فمع زيادة عدد الخلايا السرطانية في نخاع العظام، تزدحم خلايا نخاع العظام الطبيعية، مما أدى إلى عدد أقل من الخلايا المنتجة للصفائح الدموية.
◊ فقر الدم اللاتنسجي- حالة يصاحبها تخفيض إنتاج جميع خلايا الدم بشكل ملحوظ
◊ مشاكل النزيف طويلة الأجل (على سبيل المثال، نزيف مزمن من قرحة في المعدة)
◊ تعفن الدم، وخاصة الذي تسببه عدوى بكتيرية خطيرة بواسطة البكتيريا سالبة الجرام
◊ التليف الكبدي
◊ اضطرابات المناعة الذاتية، مثل الذئبة، حيث يقوم جهاز المناعة في الجسم بإنتاج الأجسام المضادة التي تهاجم أعضاء أو أنسجة الجسم ذاته، مما يسبب زيادة تدمير الصفائح الدموية
◊ العلاج الكيميائي أو العلاج الإشعاعي، والذي قد يؤثر على قدرة نخاع العظم على إنتاج الصفائح الدموية
◊ يمكن ملاحظة استهلاك الصفائح الدموية في الأمراض والحالات المختلفة. على سبيل المثال، تخثر منتثر داخل الأوعية (DIC)، فرفرية نقص الصفيحات (TTP) ومتلازمة التحلل الدموي البولي (HUS) يمكن أن يؤدي إلى قلة عدد الصفائح الدموية في الدم.
◊ التعرض للمواد الكيميائية السامة مثل المبيدات، والزرنيخ، أو البنزين
๏ إذا انخفض عدد الصفائح الدموية أقل من 20 ألف لكل ميكرولتر، قد يحدث النزيف تلقائيا، ويعتبر خطرا يهدد الحياة. يمكن إعطاء الصفائح الدموية عن طريق نقل الدم لمن يعاني من نقص شديد في عدد الصفائح الدموية.
عندما يكون عد الصفائح الدموية مرتفعا، قد يعرف بكثرة الصفيحات. وعادة ما يحدث ذلك نتيجة لحالة موجودة (وتسمى أيضا كثرة الصفيحات الثانوية أو التفاعلية) مثل:
◊
السرطان:
الأنواع الأكثر شيوعا هي سرطانات الرئة والجهاز الهضمي والمبيض، وسرطان الثدي
أو سرطان العقد الليمفاوية
◊
فقر الدم، ولا
سيما فقر الدم بسبب نقص الحديد وفقر الدم الانحلالي
◊
حالات
الالتهابات مثل مرض التهاب الأمعاء (IBD) أو التهاب المفاصل الروماتويدي
◊
الأمراض
المعدية مثل السل
◊
إذا خضع الفرد
لاستئصال الطحال جراحيا
◊
استخدام حبوب
منع الحمل
بعض الحالات قد تسبب زيادة مؤقتة (عابرة) في عدد الصفائح الدموية، وقد تشمل:
◊
التعافي من
فقدان كمية كبيرة من الدم نتيجة إصابة أو عملية جراحية كبرى
◊
بعد ممارسة
نشاط بدني أو مجهود
◊
التعافي من
فرط استهلاك الكحول وفيتامين ب12 ونقص الفولات
وفي حالات نادرة يكون سبب كثرة الصفيحات الدموية هو اضطراب نخاع العظام. مثال على ذلك هو كثرة الصفيحات وتسمى أيضا كثرة الصفيحات الأساسية أو الأولية، وهو اضطراب تكاثري نادر في نخاع العظم ينتج عددا كبيرا للغاية من الصفائح الدموية. وغالبا لا توجد علامات وأعراض للحالة ويتم اكتشافها عند إجراء فحص طبي أو لأسباب أخرى.
الأفراد المصابون بهذه الحالة قد يكونون معرضين لخطر فرط التخثر الزائد (الخثار) ويرجع ذلك إلى زيادة الصفائح الدموية، ولكن قد تكون لديهم مشاكل النزيف، حيث أن الصفائح الدموية قد لا تعمل بشكل طبيعي. وكثيرا ما يرتبط هذا الاضطراب مع طفرة في جين يسمى JAK2. يجب أن يتم إجراء تحليل لتلك لطفرة إذا كان الطبيب يشك أن الفرد مصاب بذلك الاضطراب. أكثر من نصف الأشخاص المصابين بكثرة الصفيحات الأساسية لديهم طفرة JAK2. والأشخاص الذين يعانون من اضطرابات أخرى للتكاثر النقيي أو خلل التنسج النقوي ، مثل ابيضاض الدم المزمن النخاعي أو كثرة الحمر الحقيقية أو أنواع فرعية معينة من متلازمة خلل التنسج النقوي، قد يكون لديهم أيضا عد الصفيحات الدموية مرتفعا بشكل ملحوظ.
هل هناك أشياء أخرى يجب أن أعرفها عن هذا التحليل؟
بعض الأشخاص لديهم الصفائح الدموية التي تميل إلى "التجمع" أو (الاحتجاز) في الطحال، مما يؤدي إلى انخفاض فى عدد الصفائح الدموية. ومع ذلك، فإن هؤلاء الأفراد عادة لا تظهر عليهم أي علامات أو أعراض مرتبطة بهذه الحالة.
الإقامة في أماكن تقع على ارتفاعات عالية، وممارسة التمارين الرياضية، وإنجاب طفل (بعد الولادة) قد يسبب زيادة في أعداد الصفائح الدموية. ومن الأدوية التي قد تسبب زيادة عدد الصفيحات الدموية الاستروجين وحبوب منع الحمل.
قد يحدث انخفاض طفيف في عدد الصفائح الدموية لدى النساء قبل الحيض. ما يصل الى 5% من النساء الحوامل قد ينخفض لديهن عدد الصفائح الدموية في أواخر الحمل.
وهناك اضطرابات وراثية نتيجة وجود عيوب وراثية في الصفائح الدموية مثل وهن صفيحات جلانتسمان، داء برنارد سولير، متلازمة شدياك- هيجاشي، متلازمة فيسكوت ألدريك متلازمة ماي -هجلين، ومتلازمة داون. ومع ذلك، فإن حدوث هذه التشوهات الوراثية أمر نادر نسبيا.
� هل هناك علامات أو أعراض لارتفاع أو انخفاض مستويات الصفيحات الدموية يجب أن أنتبه لها؟
إن حدوث كدمات دون سبب واضح، والنزف من الأنف أو الفم أو المستقيم دون وقوع إصابات واضحة، ودورة الحيض الشديدة أو الطويلة، أو عدم القدرة على وقف النزيف من جرح صغير خلال فترة زمنية معقولة قد تشير إلى وجود نقص الصفائح الدموية.
� لدي عدد منخفض من الصفائح الدموية. كيف يمكنني زيادتها؟
عموما، ليس هناك أي تغييرات في نمط الحياة يمكنها أن تزيد عدد الصفائح الدموية لديك. علاج انخفاض عدد الصفائح الدموية عادة ما يشمل معالجة الحالة الأساسية التي سببت ذلك. إذا كانت حالتك خفيفة وكان لديك انخفاض طفيف في عدد الصفائح الدموية، فقد لا تتطلب حالتك أي علاج. إذا كان السبب يعود إلى بعض الأدوية، فإن طبيبك قد يصف لك بدائل مختلفة. إذا كان السبب يرجع إلى اضطراب المناعة الذاتية، فإن طبيبك قد يصف لك دواء يساعد على قمع نظام المناعة. الأشخاص المصابون بأمراض خطيرة و/ أو انخفاض عد الصفيحات بشكل ملحوظ قد يكونون عرضة لخطر النزيف المفرط، ولذا فقد يخضعون لنقل الدم لتعويض الصفائح الدموية.
� إن تقرير النتائج الخاص بي يذكر متوسط حجم الصفائح الدموية (MPV) وعرض توزيع الصفائح الدموية(PDW)، ما هما؟
متوسط حجم الصفائح الدموية (MPV) وعرض توزيع الصفائح الدموية (PDW) هي حسابات تجريها أجهزة تحليل الدم الآلية. يعكس MPV متوسط حجم الصفائح الدموية الموجودة في عينة الدم، بينما يعكس PDW مدى تجانس الصفائح الدموية من حيث الحجم. ويمكن لهذه الحسابات أن تمد الطبيب بمعلومات إضافية حول الصفائح الدموية و/ أو عن سبب ارتفاع أو انخفاض عدد الصفائح الدموية. وعادة ما تكون الصفائح الدموية الأكبر حديثة نسبيا تم إطلاقها مؤخرا من نخاع العظام، في حين أن الصفائح الدموية الأصغر قد تكون أقدم وتوجد في الدورة الدموية منذ بضعة أيام.
إذا كان هناك عدد كبير من الصفائح الدموية الكبيرة (MPV مرتفع) لدى شخص ما مع انخفاض فى عدد الصفائح الدموية، فإن ذلك يشير إلى أن نخاع العظام ينتج الصفائح الدموية ويطلقها إلى الدورة الدموية بسرعة. وعلى العكس، قد يكون MPV منخفضا في أشخاص لديهم انخفاض في عدد الصفائح الدموية بسبب اضطراب يؤثر على إنتاجها بواسطة نخاع العظام. وعندما يكون PDW طبيعيا، فإنه يشير إلى أن معظم الصفائح الدموية لها نفس الحجم، في حين أن PDW مرتفع يعني أن حجم الصفائح الدموية يختلف إلى حد كبير، مما قد يشير إلى وجود اضطراب يؤثر على الصفائح الدموية.
في أغلب الأحيان، يتم إجراء فحوص إضافية إذا كانت النتائج غير طبيعية. وفي حالات معينة، قد تتجمع الصفائح الدموية معا وتظهر بشكل زائف أنها منخفضة في العدد و/ أو كبيرة الحجم، ولذلك يمكن إجراء مسحة الدم لفحص الصفائح الدموية مباشرة باستخدام المجهر.
� يشير تقرير النتائج الخاص بي إلى "صفائح دموية عملاقة" ما هي؟
"الصفائح الدموية العملاقة" هو مصطلح يستخدم لوصف الصفائح الدموية عندما تكون كبيرة بشكل غير طبيعي، أي بحجم خلية الدم الحمراء العادية. وقد يحدث ذلك في بعض الحالات مثل نقص الصفيحات المناعي (ITP) أو في اضطرابات وراثية نادرة مثل مرض برنارد سولير. ومع ذلك، وكما ذكر في السؤال السابق، فإن الفحص المباشر لمسحة الدم قد يكون ضروريا لتحديد ما إذا كانت الصفائح الدموية عملاقة حقا أو أن الصفائح الدموية قد تجمعت معا أثناء الفحص. إذا كانت الصفائح الدموية متكتلة، يمكن تكرار الفحص باستخدام أنبوب جمع مختلف يحتوي على مضادات تخثر مختلفة التي تمنع أو تقلل من تكتل الصفائح الدموية.
� إن تقرير نتائج عد الدم الكامل (CBC) الخاص بي يتضمن نتيجة للصفائح الدموية غير الناضجة (IPF)، ما معنى هذا؟
IPF هو العدد النسبي للصفائح الدموية غير الناضجة (وتسمى أيضا الصفائح الدموية الشبكية) في الدم. يتم إنتاج الصفائح الدموية في نخاع العظام، وعادة لا تطلق في مجرى الدم إلا بعد نضوجها. عند حدوث انخفاض في عدد الصفائح الدموية في الدم (نقص الصفيحات)، فإنه يحفز نخاع العظام لإنتاج الصفائح الدموية بشكل أسرع. وعندما يكون الانخفاض كبيرا ولا يكفي الإنتاج لتلبية "الطلب"، سيتم إطلاق المزيد من الصفائح الدموية غير الناضجة إلى مجرى الدم.
تظهر نتيجة IPF ضمن القيم الناتجة عندما يتم تحليل الدم باستخدام جهاز تحليل الدم الآلي. ويمكن استخدام IPF لمساعدة الطبيب على تحديد السبب المحتمل لنقص الصفيحات، حيث أن الانخفاض في الإنتاج بواسطة نخاع العظام يؤدي إلى (IPF منخفض) بينما زيادة فقدان الصفائح الدموية في الدم تجعل (IPF أعلى). وعندما تشمل نتائج الفحص المعملي عدد الصفائح الدموية و IPF فقد تساعد أيضا في تحديد ما إذا كان الشخص يحتاج إلى نقل الصفائح الدموية، وتساعد في مراقبة نخاع العظام، على سبيل المثال عقب إجراء عملية زرع نخاع العظام. وتجري حاليا دراسة استخدامات أخرى لهذا الفحص، ولم تحدد فائدته السريرية النهائية بشكل واضح.
� إذا كان لدي عدد الصفائح الدموية غير طبيعي، ما هي فحوص المتابعة التي قد يطلبها الطبيب؟
إذا كان سبب هذه النتيجة غير واضح ولا يمكن تحديده من التاريخ الطبي الخاص بك والفحص البدني، قد يلجأ طبيبك لطلب فحوص إضافية. اعتمادا على السبب المشتبه به ونتائج CBC ومسحة الدم، قد يتم إجراء العديد من فحوص المتابعة، مثل:
◊ فحوص للكشف عن الحالات الالتهابية مثل بروتين سي التفاعلي CRP، وسرعة ترسيب الكريات الحمرESR أو فحوص الأجسام المضادة الذاتية التي تستهدف الصفائح الدموية
◊ فحوص للأمراض المعدية الناجمة عن البكتيريا والفيروسات
◊ فحوص لاضطرابات النزيف مثل سلف ثرمبوبلاستين البلازما PT، زمن الثرمبوبلاستين الجزئي PTT، الفيبرينوجين
◊ فحوص للفشل الكلوي
◊ فحص مستويات الحديد أو فيتامين ب12 والفولات
◊ فحوص لأمراض الكبد
◊ في الحالات الخطرة غير واضحة السبب يتم أخذ خزعة لنخاع العظام